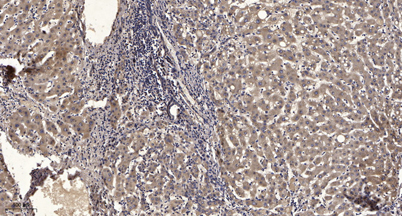

$148.00/50µL $248.00/100µL
| 50 µL | $148.00 |
| 100 µL | $248.00 |
| Product name: | SIN1 rabbit pAb |
| Reactivity: | Human; Mouse;Rat |
| Source: | Rabbit |
| Dilutions: | WB 1:500-2000;IHC-p 1:50-300; ELISA 2000-20000 |
| Immunogen: | Synthesized peptide derived from human SIN1 AA range: 193-243 |
| Storage: | -20°C/1 year |
| Clonality: | Polyclonal |
| Isotype: | IgG |
| Concentration: | 1 mg/ml |
| Molecular Weight: | 57kD |
| GeneID: | 79109 |
| Human Swiss-Prot No: | Q9BPZ7 |
| Cellular localization: | Cell membrane; Peripheral membrane protein. Cytoplasmic vesicle. Nucleus. |
| Background: | This gene encodes a protein that is highly similar to the yeast SIN1 protein, a stress-activated protein kinase. Alternatively spliced transcript variants encoding distinct isoforms have been described. Alternate polyadenylation sites as well as alternate 3' UTRs have been identified for transcripts of this gene. [provided by RefSeq, Jul 2008], |